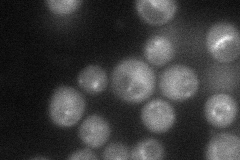
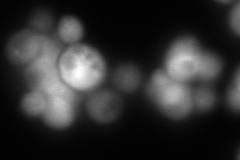
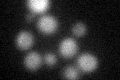

View description
Endosomal protein that is a subunit of the membrane-associated retromer complex essential for endosome-to-Golgi retrograde transport; forms a subcomplex with Vps35p and Vps26p that selects cargo proteins for endosome-to-Golgi retrieval
Localization:
Intensity:
Fold change:
Significance:
-
C’ GFP library in SD

below threshold13.47 -
N' NOP1pr-GFP in SD
punctate57.3083 -
N' TEF2pr-mCherry in SD
cytosol9.36176 -
N' NATIVEpr-GFP in SD

punctate22.1054 -
N' TEF2pr-VC and Cyto-VN in SD

cytosol46.2274 -
C’ GFP library in SD+DTT
cytosol14.241.05No -
C’ GFP library in SD+H2O2

cytosol12.950.96No -
C’ GFP library in Starvation Media

cytosol17.151.27No -
C’ GFP library on the background of Pup2-DaMP

below threshold -
C’ GFP library on the background of CCT mutant

below threshold13.27650.984929No
